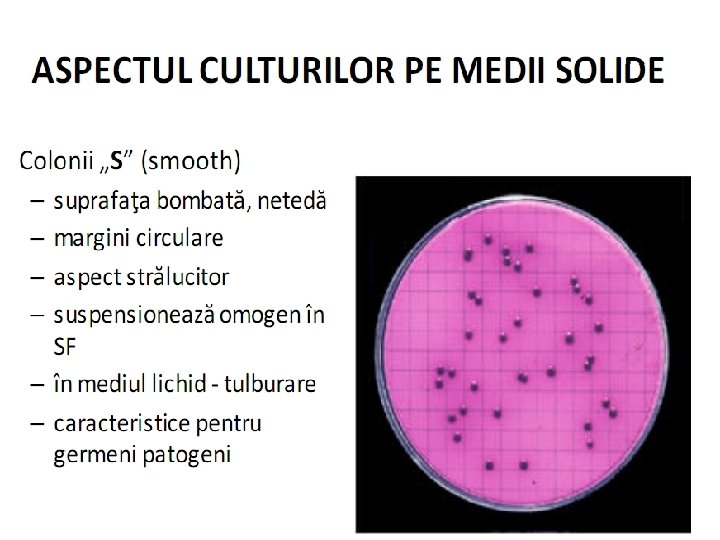
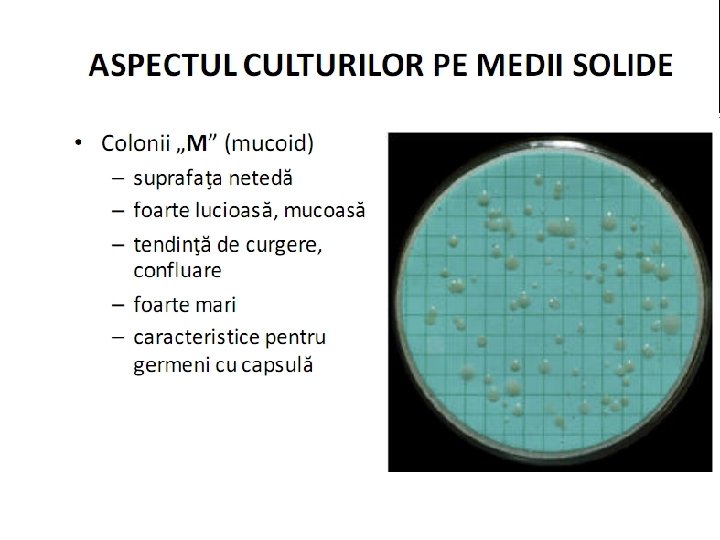

CURS DE MICROBIOLOGIE Microbiologia Microbiologie micro mic bios

CURS DE MICROBIOLOGIE

Microbiologia � Microbiologie (micro = mic; bios = viaţă) Bacteriologie (bakterion = bastonas) Virusologie Parazitologie Micologie (mykes = ciupercă) Ramuri: microbiologia solului, marină, industrială, agricolă, medicală etc.

Noţiuni de bază �Microorganismele includ virusuri, bacterii, protozoare, fungi sunt ubicuitare ▪ majoritatea nepatogene ▪ unele condiţionat patogene ▪ un mic procent patogene

MICROBIOLOGIA �Scop: studierea proceselor fizice, chimice, biologice legate de activitatea microorganismelor �pentru: a păstra si folosi pe cele utile a anihila pe cele dăunătoare �Microorganismele – rol important pe planetă – nu ar exista viaţă fără ele

Rolul pozitiv al microorganismelor �Producere de oxigen: cianobacterii �Circulaia biologică a materiei în natură: saprofiţi descompunerea substanelor organice din sol în produsi simpli (ciclul oligoelementelor: C, N, S, P, Fe) �Activitate geologică – formarea de zăcăminte petroliere, cărbuni, salpetru, sulf, minereuri de fier etc.

Rolul pozitiv al microorganismelor � În industrie fabricarea alcoolului etilic vinificaţie industria berii panificaţie produse lactate: iaurt, lapte acru, brânzeturi murături � Protecţia mediului descompun deseurile rezultate din activitatea industrială

Rolul pozitiv al microorganismelor �În agricultură îngrăsăminte �În industria medicamentelor: biosinteza microbiană a vitaminelor B 1, B 2, B 12, C, A, D 2 substanelor antibiotice

Rolul pozitiv al microorganismelor �În medicină inginerie genetică ▪ hormoni de crestere ▪ Insulină ▪ interferoni ▪ produse utilizate pentru realizarea ▪ de vaccinuri

Rolul pozitiv al microorganismelor �În medicină pe si în organismul uman trăiesc de 10 ori mai multe microorganisme decât totalul numărului de celule (epiteliale, nervoase, musculare etc. ) pe si în organismul uman trăiesc între 500 – 1000 specii diferite de microorganisme MICROFLORA INDIGENĂ (flora normală a organismului)

Rolul negativ al microorganismelor � În medicină MICROFLORA INDIGENĂ rol negativ: condiţionat patogeni = oportunisti o colonizează macroorganismul o cauzează boală doar în anumite condiţii • pătrund în zone anatomice unde nu aparţin • deficienţe ale sistemului imun • stress • oboseală • boli grave etc.

Rolul negativ al microorganismelor �pagube economice degradare microbiană a documentelor de piatră acţiune corozivă asupra metalelor descompunerea alimentelor biodeteriorarea ▪ ▪ ▪ cauciucului a maselor plastice a textilelor a hârtiei a operelor de artă etc.

Rolul negativ al microorganismelor �boli ale plantelor pestilor animalelor omului

Morfologia bacteriană

Bacteriile � Organisme procariote nu au membrană nucleară proprie prezintă un singur cromozom �Forma bacteriilor controlată genetic important criteriu taxonomic

Forma bacteriilor �forma sferică coci �forma cilindrică bacili �forma spiralată (încurbată) vibrioni spirili spirochete

Cocii - forma Diametre egale Staphylococcus spp. Streptococcus spp. Reniformi Neisseria spp. Lanceolai Streptococcus pneumoniae Ovalari Enterococcus faecalis

Cocii – dispoziţia spaţială Diplo Neisseria spp. Tetrade Micrococcus tetragenus Câte opt Sarcina spp. Grămezi Staphylococcus spp. Lanuri Streptococcus spp. Izolai Micrococi

Bacilii - forma

Bacilii – dispoziţie spaţială Diplobacili Klebsiella pneumoniae Streptobacili Bacillus anthracis Aspect litere, chibrituri, palisade Corynebacterium diphtheriae

Forme spiralate CORP ÎNCURBAT ÎNTR-UN SINGUR PLAN formă de virgulă vibrioni CORP ÎNCURBAT ÎN MAI MULTE PLANURI spirală cu spire rigide spirili spirală cu spire fine, flexibile Treponema Leptospira Borrelia

Dimensiunile bacteriilor �Micrometri 1 mm = 1. 000 micrometri (microni) μm 1 micron = 1. 000 milimicroni (nanometri) �Coci: 0, 5 – 2 μm Bacili: lungime 0, 5 – 10 μm / lăime 0, 3 – 2 μm Vibrioni: lungime 1, 5 – 3 μm / grosime 0, 5 μm Spirochete: lungime 6 – 20 μm / grosime 0, 15 – 0, 5 μm

STRUCTURA CELULEI BACTERIENE

Celula � Celula este unitatea structurala şi funcţională a tuturor organismelor vii � celula exprimă caracteristicile de bază ale vieţii foloseşte nutrienţii din mediu pt a obţine energie poate creşte; se poate reproduce răspunde la stimulii din mediu ▪ lumină ▪ căldură/frig ▪ substanţe chimice poate suferi mutaţii genetice ▪ supravieţuire ▪ apariţie de noi specii etc.

Celula eucariotă �EU – adevărat �CARYON – nucleu ▪ ADN-ul celular este înconjurat �de membrană �Dimensiuni nucleară ▪ 10 -30 µm ▪ de 10 ori mari decât celula procariotă

Celula procariotă � de 10 ori mai mică faţă de celula eucariotă � structură simplă elemente obligatorii ▪ Perete celular ▪ membrana citoplasmatică ▪ citoplasma ▪ material nuclear elemente facultative ▪ capsulă ▪ flageli ▪ pili ▪ spori

Elemente obligatorii ale celulei bacteriene �perete bacterian �membrana citoplasmatică �citoplasma bacteriană �material nuclear

1. Peretele celular � � grosime 15 – 35 nm alcătuit din proteine, lipide, hidraţi de carbon Structura � strat bazal � stratul structurilor speciale � În funcţie de proporţia celor 2 straturi şi de elementele componente ale structurilor speciale, distingem: Bacterii Gram pozitive Bacterii Gram negative Bacterii acido-alcoolo-rezistente Bacterii cu perete celular alterat

Peretele celular-stratul bazal �= mucopeptid = mucocomplex = peptidoglican �Reţea tridimensională alcătuită din macromolecule lungi, polizaharidice paralele: Acid N-acetil-muramic N-acetil-glucozamină legate prin punţi polipeptidice

Peretele celular al bacteriilor Gram pozitive � gros (15 – 30 nm), rigid, � Peptidoglicanul: 80% simplu Structură tridimensională � Structurile speciale: 20% Acizi teichoici ▪ De perete ▪ legaţi de peptidoglican ▪ De membrană ▪ legaţi şi de peptidoglican şi de membrana citiplasmatică � Acizi teichuronici � Lipoglicani (glicolipide)

Peretele celular al bacteriilor Gramnegative � Subţire, flexibil, complex Peptidoglicanul: 20% Structură bidimensională � Spaţiul periplasmatic Include peptidoglicanul � Structurile speciale: 80% Lipoproteine ▪ Unesc membrana externă de peptidoglican � Membrana externă 2 rânduri de fosfolipide între care sunt intercalate proteine (porine) � Lipopolizaharid - LPS La suprafaţa externă a membranei externe Rol antigenic (endotoxină)

Rolul peretelui celular � susţine mecanic celula bacteriană � menţine forma bacteriei � asigurăprotecţia celulei bacteriene � intervine în procesele de osmoză şi � este sediul difuziune unor antigene somatice receptorilor specifici pentru bacteriofagi � participă la diviziunea bacteriei � imprimă caracterele de tinctorialitate bacteriene ale celulei

�Alterarea sau absenţa peptidoglicanului duce la pierderea rigidităţii peretelui şi implicit la liza bacteriei. �O bacterie complet lipsită de perete – protoplast şi este incapabilă de a se divide.

2. Membrana citoplasmatică � Înconjoară citoplasma � Grosime 5 – 10 nm � Alcătuită după modelul � mozaicului fluid: două straturi de molecule fosfolipidice între moleculele de fosfolipide se găsesc proteine

Rolul membranei citoplasmatice �Reglează presiunea osmotică �Controlează procesele de difuzie �Conţine enzime ale metabolismului respirator �Intervine în creşterea şi diviziunea bacteriei �Este locul de sinteză al endotoxinelor

3. Citoplasma � Sistem coloidal complex: proteine, glucide, lipide, apă, minerale � Structură granulară: Ribozomi– 15 nm; izolaţi sau ca reticul endoplasmatic; rol esenţial în biosinteza proteinelor celulare Granulaţii de volutină (corpusculi Babeş-Ernst, granulaţii metacromatice) – polimetafosfaţi Granulaţii (incluzii) de glicogen, amidon, lipide etc. Vacuole – conţin diferite substanţe în soluţii învelite de membrană lipoproteică = tonoplast � Conţine bazofilă mari cantităţi de ARN – citoplasma intens

4. Materialul nuclear � Nu este delimitat de o membrană diferenţiată, deci NU se poate vorbi de nucleu ! � Alcătuit dintr-un cromozom unic � Format dintr-o unică moleculă de ADN dublu helicată, închisă � Diviziunea nucleului precede diviziunea citoplasmei şi a peretelui

Elemente facultative �capsula bacteriană �cilii (flagelii) �fimbriile (pilii) �sporul

Capsula bacteriană �Capsula bacteriană capsulă ▪ substanţă gelatinoasă, mucoidă la exteriorul celulei bacteriene, bine delimitată, vizibilă la microscop

Rolul capsulei bacteriene � Protejează celula bacteriană de uscăciune � Măreşte virulenţa bacteriilor patogene prin împiedicarea fagocitozei. � Substanţele chimice din capsulă-antigene si formează anticorpi � Serurile imune reactionează sp. cu antigenele capsulare producînd in vitro o mărire în vol. a capsulei. � Fenomenul de , , umflare a capsulei, , e folosit pt. Ident. sp. şi tulpinii unor germeni capsulaţi.

Cilii �alcătuiţi din flagelină– proteină complexă similară cu miozina musculară �reprezintă antigenul flagelar “H” �pornesc din citoplasma bacteriei, din corpusculul bazal

Sporul bacterian �Forma de rezistenţă şi de conservare a speciei �Nu se colorează cu coloraţii obişnuite; evidenţiat prin metode obişnuite �O bacterie formează un singur spor – un spor dă naştere unei bacterii �Diferă ca formă, dimensiune, poziţie

Compoziţia chimică a bacteriilor �Apă �Substanţe minerale �Glucide �Proteine �Lipide �Pigmenţi �Enzime �Substanţe cu acţiune �Vitamine �Factori de creştere antibiotică

Apa � 75 -85% din greutatea umedă a bacteriei Apă liberă – mediu de dispersie Apă legată fizico-chimic de diferite structuri �Rol Mediu de dispersie Reactiv în reacţii metabolice Etapă finală a unor reacţii

Substanţele minerale � 2 – 30% din greutatea uscată a bacteriei �P, K, Na, S, Cl, Fe, oligoelemente, Cu, Mg, Zn �Variază cu: Specia Vârsta culturii Compoziţia chimică a mediului �Rol: Intră în compoziţia diferitelor structuri şi enzime ▪ rol important în viaţa celulei

Glucidele � 10 – 25% din greutatea uscată a bacteriei � Variază cu: Specia Vârsta Condiţiile de dezvoltare � Glucide simple (mono şi dizaharide) Rol în metabolism � Glucide complexe (polizaharide) ▪ În structura ▪ ▪ Peretelui bacterian ▪ ▪ Capsulei � Au rol plastic şi energetic

Proteinele � 40 – �Rol 80% din greutatea uscată a bacteriei Jumătate funcţionează ca enzime Restul – rol structural �Pot fi: Simple ▪ albumine, globuline, etc. Complexe ▪ heteroproteine

Lipidele � 1 – 10% din greutatea uscată a bacteriei Excepţie – mycobacteriile – 20 - 40% � Variază cu: Specia Vârsta culturii Compoziţia mediului � Pot fi: Libere ▪ în vacuole Combinate ▪ facând parte din diferite structuri ale celulei Perete, membrană, etc.

Enzimele bacteriene � Elaborate sub � Clasificare control genetic După locul de acţiune: ▪ Intracelulare – rămân în celulă ▪ Ectocelulare – în membrana citoplasmatică ▪ Reglează permeabilitatea selectivă ▪ Extracelulare (exoenzime) – eliberate în mediu În raport cu reacţia catalizată: ▪ Hidrolaze, transferaze, oxido-reductaze, izomeraze, etc. După modul de apariţie: ▪ Constitutive – există întotdeauna în celulă ▪ Adaptative – sintetizate de către bacterie numai ca răspuns la anumiţi compuşi apăruţi în mediu

Substanţe cu acţiune antibiotică � Bacteriocine Cu efect asupra altor bacterii receptive înrudite ▪ Colicinele – eleborate de E. Coli � Antibiotice polipeptidice Produse de unele specii de Bacillus ▪ Polimixina – produsă de B. Polymyxa ▪ Bacitracina – produsă de B. licheniformis

Vitaminele bacteriene �Secretate de unele specii: Tiamina (vitamina B 1) ▪ E. coli, B. Subtilis Biotina ▪ E. coli, B. Anthracis Vitamine de grup B, K ▪ Sintetizate sub influenţa florei bacteriane intestinale

Factori de creştere �Metaboliţi esenţiali, pe care bacteria nu îi poate sintetiza Necesari în cantităţi mici dezvoltării unor bacterii �Nu au rol plastic sau �Sunt biocatalizatori �Exemple: Vitamine (B 1, B 2, B 6) Factorul X, V Acid folic, etc energetic

Nutriţia şi metabolismul

Metabolismul �Bacteriile desfăşoară o activitate metabolică în cursul căreia: Cresc Se multiplică Îşi schimbă structura şi compoziţia chimică �Metabolismul bacterian = totalitatea reacţiilor biochimice care au loc în celulă. �Metabolismul: Anabolismul Catabolismul

Nutriţia bacteriilor � Nutriţie = totalitatea proceselor metabolice care patricipă la producerea de substanţe energetice sau de materiale cu rol plastic, necesare sintezei constituenţilor celulari. � Bacteriile folosesc surse nutritive diverse: azot molecular, dioxid de carbon, sulf, etc. � În funcţe de tipul de nutriţie, bacteriile pot fi: autotrofe (utilizează N şi C din compuşi anorganici) şi heterotrofe (utilizează N şi C din compuşi organici)

�În raport cu sursa de energie utilizată, bacteriile autotrofe sunt: Fototrofe – utilizează energia radiantă luminoasă Chimiotrofe – utilizează energia rezultată din reacţiile de oxidoreducere. �Bacteriile patogene sunt heterotrofe, datorită parazitismului şi-au pierdut capacitatea de a-şi sintetiza elementele de care au nevoie. �Pentru cultivarea pe medii artificiale este necesară introducerea unor factori de creştere: vitamine B 1, B 2, B 6, PP, aminoacizi, etc.

Metabolismul energetic bacterian. Respiraţia şi fermentaţia � Respiraţia bacteriană = totalitatea proceselor aerobe şi anaerobe prin care celula eliberează energia necesară activităţii vitale. Aceste reacţii au la bază mecanismul oxidoreducerii. � Prin oxidoreducere biologică se înţelege pierderea atomilor de hidrogen (a electronilor de către o substanţă chimică numită donor şi transferul acestora pe molecula unei alte substanţe chimice numită accepor. )

� După natura acceptorului final de hidrogen, sunt trei tipuri de procese metabolice: Respiraţie aerobă (oxibiotică) în care acceptorul de H este oxigen molecular, produsul rezultat este apa. Respiraţia anaerobă (anoxibiotică), în care acceptorul de H poate fi orice substanţă anorganică exceptând O. Fermentaţia, în care acceptorul de electroni este un compus organic.

� În funcţie de comportarea faţă de oxigenul molecular, bacteriile pot fi: Bacterii strict aerobe (b. tuberculozei, b. cărbunos), care folosesc oxigenul molecular ca acceptor final de H. Bacterii strict anaerobe: (b. tetanic, b. botulinic), care se dezvoltă numai în prezenţa oxigenului. Bacterii aerobe facultativ anaerobe (stafilococul, b. coli) au posibilitatea să-şi adapteze metabolismul în funcţie de prezenţa sau absenţa oxigenului. Bacterii microaerofile (spirochete), care tolerează cantităţi mici de oxigen. � Cunoaşterea fiziologiei bacteriilor oferă posibilitatea să le creăm condiţii optime de cultivare şi să aplicăm unele teste pentru identificarea lor

Înmulţirea bacteriilor � Se face în mod obişnuit prin diviziune directă. � La bacili este transversală, iar la coci se face după unul sau mai multe planuri perpendicu-lare care duce la gruparea caracteristică în perechi, lanţuri sau grămezi. � Pentru a vorbi despre creştere şi multiplicare bacte-riană folosim următoarele noţiuni: Timp de generaţie: timpul necesar dublării populaţiei bacteriene – 20 -30 de minute. Rata de creştere: nr. de generaţii în unitate de timp. Colonia bacteriană: totalitatea bacteriilor rezultate din multiplicarea unei singure celule. Cultura bacteriană: totalitatea coloniilor de pe suprafaţa mediului solid. Cultura mixtă: formată din mai multe tipuri de colonii. Cultura pură: formată dintr-un singur tip de colonie.

Dinamica multiplicării bacteriene �Multiplicarea populaţiei bacteriene 4 faze caracteristice ▪ Faza de latenţă (faza de lag) ▪ Faza de creştere logaritmică (faza exponenţială) ▪ Faza staţionară (faza de concentraţie “M”) ▪ Faza de declin

Faza de latenţă �Perioada de adaptare a bacteriilor la condiţiile de mediu �Numărul germenilor rămâne nemodificat sau scade �Durează 2 ore �Între momentul însămânţării şi momentul când bacteria incepe să se multiplice

Faza de creştere logaritmică �Celulele bacteriene încep să se dividă ritmic �Timpul de generaţie -20 – 30 minute Excepţie Mycobacterium tuberculosis: 12 -27 ore �Numărul de naşteri > numărul de decese �Virulenţa este conservată �Durează 8 – 12 ore

Faza staţionară � Consumul substanţelor nutritive —> acumulare de metaboliţi toxici —>mediu de viaţă mai puţin favorabil � Numărul de bacteriirămâne constant � Numărul de naşteri = numărul de decese � Morfologia este caracteristică � Începe sporogeneza � 2 – 3 zile � mediu de cultură reînnoit permanent ⇒cultură continuă

Faza de declin �Cantitatea de metaboliţi toxici este mare �Numărul de naşteri < numărul de decese �Sporogeneza este foarte intensă �Apar modificări morfologice, metabolice, de virulenţă � 2 – 3 zile/2 – 3 săptămâni/2 – 3 luni

CULTIVAREA BACTERIILOR �SCOP: �identificarea agentului etiologic al unei infecţii �determinarea farmacorezistenţei �microorganismelor izolate �preparare seruri şi vaccinuri

DEFINIŢII � POPULAŢIA BACTERIANĂ: multitudinea de indivizi ai unei specii care habitează într-un biotop � CLONA BACTERIANĂ: populaţia rezultată dintr-o singură celulă prin înmulţire vegetativă (colonie bacteriană) � TULPINA BACTERIANĂ: populaţia microbiană alcătuită din descendenţii unei singure izolări în cultură pură � INOCULARE: depunerea unui produs biologic în cultura de celule, animale de laborator

DEFINIŢII � ÎNSĂM NŢARE: depunerea unui produs biologic pe / în mediu de cultură � MEDIU DE CULTURĂ: mediu care asigură nutrienţii şi condiţiile fizico-chimice necesare creşterii şi multiplicării bacteriene � CULTURA BACTERIANĂ: totalitatea bacteriilor acumulate prin multiplicare pe / în mediul de cultură

GENUL STAPHYLOCOCCUS

Definitie �Coci Gram-pozitivi grămezi neregulate aerobi, facultativ anaerobi imobili nesporulaţi catalazo-pozitivi

Definiţie �Grupe de interes medical: Stafilococi coagulazo - pozitivi ▪ Staphylococcus aureus Stafilococi coagulazo - negativi: ▪ Staphylococcus epidermidis ▪ Staphylococcus saprophyticus

Habitat: �Staphylococcus aureus: colonizează nările şi colonul → contaminare tegument purtători sănătoşi: în colectivitate – 10 -40% ; în spital – 40 -70% rezervor principal: mamifere şi păsări → contaminare mediu

Habitat � Staphylococcus aureus: suport material al transmiterii sol, apa de mare şi apa dulce, suprafaţa plantelor, fructe, alimente, îmbrăcăminte, mobilier, covoare, praful şi aerul din încăperi

Habitat: �colonizează nările şi tegumentul �constituenţi ai florei normale cutanate �(barieră de apărare antimicrobiană)

Caractere morfo-tinctoriale: �Coci gram-pozitivi �Frotiu: din cultură pe mediu solid: dispuşi în grămezi neregulate din cultură în mediu lichid sau din produs patologic: extracelular (rar intracelular) lanţuri scurte, perechi coci izolaţi

Caractere de cultură �pe medii solide: colonii: „S”; �în medii lichide : tulburare uniformă cu depozit moderat la fundul tubului

Rezistenţă faţă de ag. fizici, chimici , biologici �rezistă în culturi, la frigider – câteva luni; în puroi uscat – 2 -3 luni; �relativ rezistenţi la antiseptice/dezinfectante (30’ la alcool 70º) �distruşi în 60 minute la temperatura de 60ºC �sensibili la bacteriofagi, la UV

Rezistenţă �DEOSEBIT DE REZISTENŢI LA ANTIBIOTICE !!! �Peste 95% rezistenţi la penicilină �Tulpini rezistente la meticilină (oxacilină) = polirezistente (cefalosporine, eritromicina, clindamicina) �MRSA (stafilococ auriu meticilinorezistent) �Sensibil la vancomicină

Procesul infecţios de tip stafilococic �PROCES INFECŢIOS DE TIP INVAZIV �TOXIINFECŢII DE ETIOLOGIE STAFILOCOCICĂ

Proces infecţios de tip invaziv � Foliculita – infecţia foliculului pilos � Furuncul – abces în jurul foliculului pilos � Hidrosadenită – infecţia glandei sudoripare � Panariţiu – infecţie peri- sau subunghială � Impetigo stafilococic � Mastită � Infecţii ale plăgilor chirurgicale, muşcate, tăiate � Angina stafilococică → otite, mastoidite, sinusite � Infecţii urinare, uretrită, cistită, pielonefrită etc.

�Focare septicemice pulmonar (pneumonii, pleurezii) renal osos, articular meningo-cerebral aparat circulator (endocard, pericard, endoteliu vascular)

Toxiinfecţii de etiologie stafilococică Toxiinfecţia alimentară stafilococică Ingestia enterotoxinei termorezistente elaborată în aliment Suficientă cantitate foarte mică �Sursa: om – furuncul, sinusită, rar portaj asimptomatic animal – mastită, furunculoză alimente: lactate, carne, ouă, peşte �latenţă 1 -2 ore, perioadă de stare 24 -72 ore, refacere 12 -24 ore

Leziuni de natură toxică cutanate „sindromul pielii opărite stafilococice” �= � � � boala exfoliativă generalizată(boala Ritter) este necroza de origine toxică a epidermului cauzată de toxina exfoliativă apare iniţial eritemperioral care se extinde apoi la totcorpul apariţia bulelor mari cu lichid clar este urmată de ruperea straturilor superficiale epidermei vindecarea are loc la intervale de 10 zile de la apariţia anticorpilor protectori

Sindrom de şoc toxic stafilococic STTS �hipertermie �hipotensiune �vărsături, diaree �mialgii �insuficienţă hepatică şi renală acută �descuamarea tegumentelor palmare şi plantare �stare de şoc

Tratament: � Efectuarea antibiogramei este obligatorie pentru toate tulpinile de stafilococi izolate din diverse infecţii � Rezistenţă crescută prinproducerea de beta-lactamaze, enzime care neutralizează antibioticele gen penicilină, cefalosporine � modificarea unor proteine ale peretelui celular � Antibioticele de elecţie sunt Oxacilina şi Nafcilina

Tratament: �Infecţiile grave sau infecţiile asociate cu bacteriemie/septicemie �tratament cu antibiotice pe cale parenterală (injectabilă) �infecţiile pielii, ale ţesuturilor moi sau ale căilor respiratorii �tratament prin administrare orală

Profilaxie: �măsuri de igienă riguroasă în unităţile sanitare �spălarea mâinilor înainte şi după contactul cu pacienţii �utilizarea mănușilor �determinarea portajului nazal de S. Aureus �administrarea profilactică de antibiotice pre si post-operator.


GENUL STREPTOCOCCUS

Definiţie. Încadrare. �coci sferici Gram-pozitivi formează perechi sau lanţuri în cursul diviziunii celulare pretenţioşi nutritiv, imobili şi nesporulaţi unele specii au capsulă

În raport cu patogenitatea �streptococi patogeni � streptococi condiţionat sau accidental patogeni

Criteriu filogenetic de clasificare �realizat pe baza analizelor efectuate prin metode ale biologiei moleculare � 6 grupări de specii în cadrul genului I. Grupul piogenic II. Grupul anginosus III. Grupul mitis IV. Grupul salivarius V. Grupul bovis VI. Grupul mutans

Grupul piogenic - S. pyogenes �Boli invazive datorate streptococilor piogeni Erizipelul Celulite Fasceite necrozante Febra puerperală Sepsisul streptococic.

Grupul piogenic - S. pyogenes �Boli localizate: Faringita streptococică Scarlatina Impetigo streptococic �Endocardita infecţioasă Foarte rară Severitate înaltă

Grupul mitis �Prin leziuni ale mucoasei bucale (extracţii dentare) pătrund în sânge endocardită subacută la pacienţi cu leziuni ale endocardului valvular sau cu disfuncţii ale dinamicii sanguine cardiace

Grupul salivarius �Cuprinde Streptococcus salivarius Streptococcus vestibularis �specii rezidente ale cavităţii bucale şi orofaringelui �accidental patogene �implicaţii clinice asemănătoare cu cele ale streptococilor viridans

Grupul bovis �streptococii de grup D �nonhemolitici

Grupul bovis �S. bovis prezintă interes medical izolat de la bovine, porci, câini, porumbei se poate transmite accidental la om aparţine florei normale a colonului ocazional produce, la pacienţii cu leziuni ale colonului ▪ endocardită subacută ▪ bacteriemie

Grupul mutans �habitat omul animale ▪ hamsteri, ▪ şobolani, ▪ maimuţe

Grupul mutans �Importanţă în patologia umană: Streptococcus mutans ▪ rezidenţi în cavitatea bucală ▪ implicate în formarea plăcii dentare şi în cariogeneză ▪ izolate rar de la pacienţi cu endocardită subacută

Caractere de cultură �colonii S mici, rotunde, opace, strălucitoare


GENUL SALMONELLA

Habitat � tractul intestinal al oamenilor şi animalelor � toate serovarurile de Salmonella enterica subspecia enterica sunt parazite pentru om şi mamifere � celelalte subspecii se întâlnesc preponderent la păsări şi animale cu sânge rece. � omul şi animalele determină poluarea solului, apelor reziduale, apelor de suprafaţă în care pot supravieţui de la câteva luni până la câţiva ani de zile, dacă condiţiile de temperatură, umiditate şi p. H sunt favorabile

Rezistenta �germeni rezistenţi; în solul păşunilor pot supravieţui până la 200 de zile, în apă câteva luni în alimente între 10 şi 180 de zile, în pulberile de ouă 4 ani. �sensibile la căldură distruse în 5 minute la 100°C; �dezinfectantele le distrug în minute 30 -120 de

Boala la om �Salmonelozele includ 5 sindroame: �gastroenterite; �febre enterice; �septicemie; �infecţii focale;

Gastroenteritele determinate de Salmonella � pătrund pe cale digestivă � ingeraţi într-un număr mai mare de 10 pot declanşa boala la adultul sănătos. � aciditatea gastrică distruge majoritatea germenilor ingeraţi. � contaminarea masivă se realizează : prin ingestia alimentelor în care germenii s-au multiplicat ca într- un mediu de cultură de la persoană pe cale fecal-orală � Nou născuţii şi copii mici sunt mult mai sensibili la infecţie care poate fi indusă de ingerarea unui număr mic de bacterii

Incubatia - de la câteva ore până la o zi � microorganismele se multiplică în epiteliul intestinal, provoacă un sindrom inflamator intestinal cu diaree mucopurulentă şi sangvinolentă � la debut diareea este însoţită de greţuri şi vărsături; � în perioada de stare a bolii - febră, colici abdominale, mialgii şi cefalee � la nou născuţi deshidratarea poate duce la o stare de toxicoză gravă

� Salmoneloze majore (febre enterale)–febra tifoidă, febrele paratifoide � simptomatologie digestivă (datorată agresiunii intestinale, hepatice şi asupra vezicii biliare) anorexie, colici abdominale, constipaţie sau diaree. � Plăcile Peyer pot să ulcereze şi să ducă la perforaţie intestinală şi peritonită

Salmoneloze majore(febrele enterale)-febra tifoida � Eliberarea endotoxinelor rol important în patogenia bolii pericolul administrării unei doze foarte mari de antibiotic � distrugere bacteriene masive - deci eliberarea în cantitate � foarte mare de lipopolizaharide ale membranei externe � bacteriene - instalarea şocului endotoxinic � după vindecarea bolii pacientul poate rămîne purtător biliar de germeni timp de aproximativ un an de zile.

Tratament � În febrele enterice spitalizarea şi administrarea intravenoasă de antibiotice trebuie să se realizeze cât mai repede posibil. Cloramfenicol Ampicilina Cotrimoxazol Fluorochinolone � Purtătorii de Salmonella � intervenţie chirurgicală � tratament cu ampicilină. � eficacitate de 85% serovar Typhi în vezica biliară

Profilaxie �cele mai importante rezervoare animale găinile, curcanii, porcii şi vacile; �se pot întâlni ca rezervoare şi alte animale domestice şi sălbatice. �supravieţuiesc în ouă, pulberi de ouă, carne crudă şi produse animaliere incomplet preparate termic �transmitere: produsele animale

Profilaxie � reducerea purtătorilor animali reduce semnificativ expunerea umană. � schimbarea practicilor de tăiere a animalelor pentru a reduce contaminarea de pe carcasele acestora; � protejarea de contaminare în procesele de prelucrare a � alimentelor; � asigurarea unui program de învăţare a practicilor igienice � pentru personalul care manevrează alimentele în abatoare, fast-food-uri, cofetării, restaurante; � prepararea şi refrigerarea adecvată a alimentelor în restaurante şi case;

Habitat �T. pallidum are ca unică gazdă omul �În mediul extern nu rezistă fiind foarte sensibilă la uscăciune şi la acţiunea dezinfectantelor

Rezistenţa faţă de agenţii fizici, chimici şi biologici �Treponema pallidum este distrusă de uscăciune temperaturi de 42°C antiseptice, dezinfectante. Este sensibilă faţă de antibioticele betalactamice, în special faţă de penicilină.

Patogenie. Boala la om �T. pallidum este agentul etiologic al sifilisului venerian transmite prin contact sexual, contact direct cu leziunile ulcerative ale persoanei infectate �se sifilisului congenital �se transmite la făt, transplacentar de la gravidele infectate, în perioadele de bacteriemie

Patogenie. Boala la om venerian : �Boala evoluează în mai multe etape: �Sifilisul sifilisul primar sifilisul secundar, latent sifilisul terţiar

Patogenie. Boala la om � sifilisul primar După o incubaţie de 3 săptămâni se dezvoltă leziunea primară, denumită şancru de inoculare (şancru dur) Ulceraţie nedureroasă, cu marginile ridicate, indurate şi baza netedă după 1 săptămână apare adenopatia regională dură, discretă, nedureroasă se “vindecă” spontan în 3 -6 săptămâni –bacteriile sunt prezente în ţesutul limfatic

Patogenie � • sifilisul secundar apare la 4 - 10 săptămâni după apariţia şancrului dacă pacientul nu urmează tratament – leziuni muco-tegumentare diseminate şi de aspect variat dar care sunt infectante După manifestările clinice urmează o perioadă de latenţă, sifilisul latent � bolnavul este asimptomatic şi necontagios, cu excepţia transmiterii transplacentare sau prin sânge.

Patogenie � sifilisul terţiar apare la 5 – 30% din pacienţii netrataţi, după 1 - 40 de ani (în medie 15 ani) de la infecţia primară Afectează sistemul cardiovascular (în special aorta) şi sistemul nervos central Leziunea histologică caracteristică este goma � ulceraţie necrotică � apare pe tot corpul dar şi în ficat, oase sau testicule

Patogenie �sifilisul congenital se manifestă asemănător cu sifilisul secundar al adultului. în sifilisul congenital tardiv predomină manifestările neurologice acompaniate de modificări caracteristice ale sistemului osos, ale dinţilor sau oculare

Tratament �Penicilina �La nevoie G administrată parenteral. penicilina se poate înlocui cu alte antibiotice. �Pacienţii trebuie urmăriţi serologic şi clinic pentru a aprecia eficienta tratamentului.

Epidemiologie � Sursa de infecţie este omul bolnav în stadiu de sifilis primar sau secundar � Boala se transmite prin contact sexual, transplacentar şi prin sânge infectat (transfuzii) � Receptivitatea este generală, infecţia existând la orice vârstă � evitarea contactelor sexuale neprotejate � evitarea partenerilor multipli, anonimi, � în cazul îmbolnăvirii, tratarea tuturor partenerilor sexuali � Depistarea gravidelor


Habitat: Leptospira interrogans este găzduită de: Mamifere reptile şi amfibieni � gazdele se împart în trei categorii: � de menţinere ▪ poartă leptospirele în rinichi şi în organele de reproducere, fiind aparent sănătoase ▪ infecţia se transmite prin urină sau pe cale sexuală ▪ rozătoarele accidentale ▪ om sau animale domestice care se infectează prin elementele din mediu de amplificare. ▪ gazde accidentale la care infecţia se poate transmite epidemic ▪ în crescătoriile de animale domestice � acestea transmit infecţia şi către om şi către gazdele de menţinere

Habitat �Animalele contaminează prin urină: apa solul umed nămolul �leptospirele pot supravieţui până la 42 de zile la întuneric, mediu cald şi p. H neutru sau usor alcalin �L. biflexa trăieşte în apele de suprafaţă

Rezistenta la agenti fizici, chimici mediul extern leptospirele supravieţuiesc greu sensibile faţă de: � în uscăciune lumină solară p. H acid sau intens alcalin temperatura sub 14°C sau peste 28°C � distruse de alcool acizi Baze cloramină � Sunt sensibile faţă de betalactamine

Patogenitate. Boala la om. � Leptospiroza zoonoza cu cea mai largă răspândire � Boala la om frecvent ▪ ▪ prin contactul indirect cu apa sau solul contaminate ▪ ▪ prin contactul cu urina animalelor infectate rar ▪ ▪ prin contact direct cu animalele purtătoare Leptospirele pătrund în organismul uman prin tegumente şi mucoase intacte sau uşor scarificate, conjunctivă, mucoasa nazală, plămâni (aerosoli) � pot străbate placenta şi pot provoca avort sau deces fetal ante-partum. �

Patogenie � În gazdele susceptibile � prin sistemului limfatic, leptospirele ajung în sistemul circulator cauzând o leptospiremie urmată de răspândirea lor în toate organele � posibilitatea afectării mai multor organe explică polimorfismul clinic al bolii � manifestările clinice - variabile forme uşoare forme grave ▪ insuficienţă renală sau hepatică

Diagnosticul de laborator � Leptospirele se pot evidenţia în sânge ▪ ▪ în primele 5 zile de boală în lichidul cefalorahidian ▪ ▪ între a 4 -a si a 8 -a zi de boală din urină ▪ ▪ începând din ziua a 9 -a de boală, timp de 6 săptămâni � Examenul direct preparat nativ ▪ ▪ examinat la microscopul cu fond întunecat, frotiu

Tratament � Antibioterapia este principalul mijloc terapeutic în leptospiroză � formele necomplicate care nu necesită spitalizare doxicilină pe cale orală � în formele cu evoluţie mai gravă penicilină G pe cale intravenoasă. � în formele grave, cu insuficienţe ale organelor la tratamentul antibiotic se asociază şi tratamentul suportiv

Epidemiologie Leptospiroza este probabil zoonoza cea mai răspândită în lume � multe cazuri rămân nediagnosticate datorită posibilităţii de evoluţie autolimitantă a bolii, simptomelor necaracteristice � Sursa de infecţie: rozătoarele, sobolanii, câinii, pisicile şi mamiferele sălbatice ▪ ▪ prin urină contaminează apa şi solul � transmiterea bolii la om – indirect prin ape contaminate � Expunerea în general este profesională: ▪ la fermieri, medici veterinari, muncitorii din abatoare, agricultori, lucrătorii din orezării.



Borrelia burgdorferi


Patogenie. Boala la om �Boala �apare Lyme după muscătura de căpuşă infectată �▪ borreliile �▪ introduse în piele prin muşcătura infectantă apoi difuzeaza local in tot organismul, localizându-se în variate situsuri �sistemul nervos �articulaţiile

Patogenie � Boala evoluează în trei stadii: Primul stadiu ▪ după o incubaţie de 1 -3 săptămâni ▪ ▪ modificări locale cutanate de la locul înţepăturii ▪ ▪ eritemul migrator se întinde centrifug, sub formă inelară, zona centrală rămânând clară, palidă poate să fie însoţit de adenopatie şi de semne generale

Patogenie � Al doilea stadiu după săptămâni sau luni de la infecţie prin diseminarea generală a borreliilor ▪ ▪ ▪ ▪ � Al multiple leziuni tegumentare eritem inelar afectare cardiacă miocardită afectarea sistemului nervos paralizii de nervi cranieni meningite cu lichid clar treilea stadiu diseminare tardivă manifestări articulare cronice

Tratament: �curativ şi profilactic �diferite scheme de tratament în funcţie de stadiul bolii �antibioticele cel mai des folosite �Cefalosporinele �betalactaminele asociate cu inhibitori de �betalactamază �tetraciclinele

Prevenire. Control � � � receptivitatea este generală imunitatea post-boală nu este de lungă durată profilaxia nespecifică: evitarea muşcăturii de căpuşă în caz de muşcătură ▪ se îndepărtează căpuşa astfel încât să nu i se rupă piesele bucale ▪ se spală bine zona cutanată cu apă şi săpun ▪ se antiseptizează cu alcool ▪ se controlează locul muşcăturii timp de 1 lună pentru a sesiza apariţia unui eventual eritem � profilaxia specifică în derulare studii o serie de vaccinuri recombinante, monovalente inducerea răspunsului imun prin administrare de plasmide ce codifică proteina de suprafaţă Osp. A


GENERALITATI �bacil Gram-negativ aerob poate prezenta microcapsulă bacterie obligatoriu intracelulară nu poate fi cultivată pe medii artificiale

Ciclu de viata �implică organisme vertebrate �animale, om �nevertebrate �artropode (în căpuşele) principal păduchii, purecii,

Boala la om �tifosul exantematic boală cu evoluţie epidemică �în urma războaielor, a dezastrelor naturale comunităţi închise, lipsa igienei "camp fever", "jail fever", "hospital fever", "ship fever", �"famine fever“ vectorul bacteriei: ▪ păduchele de corp (“Pediculus humanus corporis”)

Boala la om-tifosul exantematic � simptome cefalee febră (39 C) rash cutanat � pe torace, abdomen, apoi membre � respectă faţa, palmele şi plantele dureri musculare, articulare frisoane sensibilitate la lumină delir

Tratament �antibiotic Tetraciclină �susţinerea funcţiilor vitale în cazurile grave
- Slides: 150